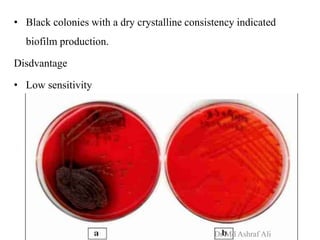
• Black colonies with a dry crystalline consistency indicated
biofilm production.
Disdvantage
• Low sensitivity
Dr Md Ashraf Ali

Microbial biofilms are sessile communities of microbes that are irreversibly attached to surfaces and embedded in an extracellular matrix. They form through a multi-stage process beginning with initial reversible attachment followed by irreversible binding and growth. Quorum sensing allows cell-cell communication to coordinate biofilm formation. Mature biofilms are resistant to antimicrobial agents and can persist as sources of infection. Biofilms commonly form on medical devices and tissues, causing device-related and recurrent infections.